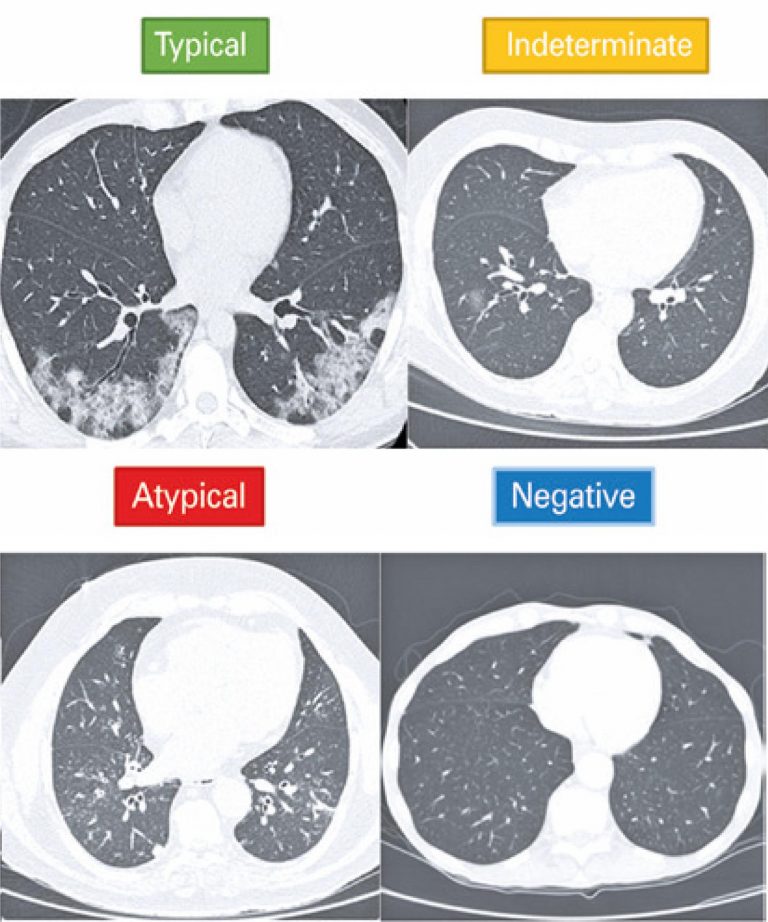

18/Jul/2022
Effect of lateral decubitus acquisition in accuracy and lung severity estimation of chest computed tomography in children with suspected COVID-19
einstein (São Paulo). 18/Jul/2022;20:eAO0061.
View Article18/Jul/2022
Effect of lateral decubitus acquisition in accuracy and lung severity estimation of chest computed tomography in children with suspected COVID-19
DOI: 10.31744/einstein_journal/2022AO0061
ABSTRACT Objective To compare inter-rater reliability, diagnostic accuracy, and extension of pulmonary involvement in children with suspected COVID-19 submitted to supine or supine and lateral decubitus computed tomography imaging. Methods Retrospective study carried out between March 2020 and March 2021 with patients submitted to reverse transcription-polymerase chain reaction testing and chest computed tomography. Patients were divided into two groups: supine or supine and lateral decubitus imaging. Standardized reporting systems of computed tomographic findings in COVID-19 and chest computed tomography score […]
Keywords: Child; Coronavirus infections; COVID-19; Multidetector computed tomography; Reverse transcriptase polymerase chain reaction; Tomography, x-ray computed
15/Dec/2021
Accuracy of echocardiography and chest tomography for pulmonary hypertension screening in patients awaiting lung transplantation
DOI: 10.31744/einstein_journal/2021AO5710
ABSTRACT Objective To examine the accuracy of a pulmonary hypertension screening strategy based on a combination of echocardiographic data and tomographic measurements (pulmonary artery diameter and pulmonary artery diameter to ascending aorta diameter ratio) in patients with chronic lung disease referred for lung transplantation. Methods A retrospective observational study with patients with pulmonary emphysema or fibrosis referred for transplantation between 2012 and 2016. Pulmonary hypertension was defined as mean pulmonary artery pressure ≥25mmHg, or between 21 and 24mmHg, with pulmonary […]
Keywords: Cardiac catheterization; Echocardiography; Hypertension, pulmonary; Thorax/diagnostic imaging; Tomography, x-ray computed; Transplantation
26/Oct/2021
Chest computed tomography in the diagnosis of COVID-19 in patients with false negative RT-PCR
DOI: 10.31744/einstein_journal/2021AO6363
ABSTRACT Objective To evaluate the role of chest computed tomography in patients with COVID-19 who presented initial negative result in reverse transcriptase-polymerase chain reaction (RT-PCR). Methods A single-center, retrospective study that evaluated 39 patients with negative RT-PCR for COVID-19, who underwent chest computed tomography and had a final clinical or serological diagnosis of COVID-19. The visual tomographic classification was evaluated according to the Consensus of the Radiological Society of North America and software developed with artificial intelligence for automatic detection […]
Keywords: Coronavirus infections; Reverse transcriptase polymerase chain reaction; Tomography, x-ray computed
09/Mar/2021
Sinus computed tomography findings in patients with COVID-19
DOI: 10.31744/einstein_journal/2021AO6255
ABSTRACT Objective: To analyze computed tomography scans of paranasal sinuses of a series of patients with coronavirus disease 2019, and correlate the findings with the disease. Methods: Computed tomography scans of 95 adult patients who underwent a polymerase chain reaction test for severe acute respiratory syndrome coronavirus 2 were analyzed. Clinical data were obtained from patients’ records and telephone calls. Paranasal sinus opacification was graded and compared according to severe acute respiratory syndrome coronavirus 2 positivity. Results: Of the patients […]
Keywords: Coronavirus infections; Paranasal sinuses; Rhinitis; Tomography, x-ray computed
05/Mar/2021
Differential diagnoses of acute ground-glass opacity in chest computed tomography: pictorial essay
DOI: 10.31744/einstein_journal/2021RW5772
ABSTRACT Ground-glass opacity is a very frequent and unspecified finding in chest computed tomography. Therefore, it admits a wide range of differential diagnoses in the acute context, from viral pneumonias such as influenza virus, coronavirus disease 2019 and cytomegalovirus and even non-infectious lesions, such as vaping, pulmonary infarction, alveolar hemorrhage and pulmonary edema. For this diagnostic differentiation, ground glass must be correlated with other findings in imaging tests, with laboratory tests and with the patients’ clinical condition. In the context […]
Keywords: Coronavirus infections; COVID-19; Diagnosis, differential; Pandemics; SARS-CoV-2; Thorax/diagnostic imaging; Tomography, x-ray computed
20/Oct/2020
COVID-19 myocarditis: a case report
DOI: 10.31744/einstein_journal/2020RC5876
ABSTRACT A male patient with flu-like symptoms and tomography and laboratory diagnosis of severe acute respiratory syndrome. He developed acute cardiac dysfunction during admission and was submitted to a cardiac magnetic resonance imaging examination, which confirmed acute myocarditis, indicating cardiac involvement by coronavirus disease 2019. A review and discussion about coronavirus disease 2019-related cardiac manifestations are reported, focusing on the imaging findings to make diagnosis.
Keywords: Cardiomyopathies; Communicable diseases; Coronavirus; Coronavirus infections; COVID-19; Echocardiography; Myocarditis; Pneumonia; Severe acute respiratory syndrome; Tomography, x-ray computed
09/Oct/2020
Quality and safety innovations in the Radiology Department during the COVID-19 pandemic: a Latin American experience
einstein (São Paulo). 09/Oct/2020;18:eGS5832.
View Article09/Oct/2020
Quality and safety innovations in the Radiology Department during the COVID-19 pandemic: a Latin American experience
DOI: 10.31744/einstein_journal/2020GS5832
ABSTRACT Radiology departments were forced to make significant changes in their routine during the coronavirus disease 2019 pandemic, to prevent further transmission of the coronavirus and optimize medical care as well. In this article, we describe our Radiology Department’s policies in a private hospital for coronavirus disease 2019 preparedness focusing on quality and safety for the patient submitted to imaging tests, the healthcare team involved in the exams, the requesting physician, and for other patients and hospital environment.
Keywords: Coronavirus; Coronavirus infections; COVID-19; Quality and safety; Tomography, x-ray computed
04/Feb/2020
Cinematic rendering for three-dimensional reconstructions of the chest wall: a new reality
DOI: 10.31744/einstein_journal/2020MD5223
ABSTRACT Computed tomography with multiple detectors and the advancement of processors improved rendered images and three-dimensional reconstructions in clinical practice. Traditional axial slices form non-intuitive images because they are seen in only one plane. The three-dimensional reconstructions can show structures details and diseases with complex anatomy in different perspectives. Cinematic rendering is a newly three-dimensional reconstruction technique, already approved for clinical use, which can produce realistic images from traditional computed tomography data. The algorithm used is based on light trajectory […]
Keywords: Image processing, computer-assisted; Tomography, x-ray computed
11/Sep/2018
Percutaneous drainage of iliopsoas abscess: an effective option in cases not suitable for surgery
DOI: 10.1590/S1679-45082018RC4254
ABSTRACT The aim of this study were to describe the technique of percutaneous drainage of iliopsoas abscess, and to discuss the benefits of using this minimally-invasive tool. A single center study with retrospective analysis of patients with psoas abscess confirmed by imaging scans, sent to the interventional medicine center and submitted to computed tomography and ultrasound-guided percutaneous drainage, from November 2013 to August 2016. Seven patients underwent percutaneous drainage of psoas abscess in this period. The mean initial drained volume […]
Keywords: Drainage; Minimally invasive procedures; Psoas abscess/diagnostic imaging; Tomography, x-ray computed; Ultrasonography
01/Oct/2016
Isolated primary amyloidosis of the inferior rectus muscle mimicking Graves’ orbitopathy
DOI: 10.1590/S1679-45082016RC3744
ABSTRACT The diagnosis of Graves’ orbitopathy is usually straightforward. However, orbital diseases that mimick some clinical signs of Graves’ orbitopathy may cause diagnostic confusion, particularly when associated to some form of thyroid dysfunction. This report describes the rare occurrence of localized inferior rectus muscle amyloidosis in a patient with autoimmune hypothyroidism, who was misdiagnosed as Graves’ orbitopathy. A 48-year-old man complained of painless progressive proptosis on the left side and intermittent vertical diplopia for 6 months. The diagnosis of Graves’ […]
Keywords: Amyloidosis; Case reports; Graves disease/diagnosis; Oculomotor muscles/physiopathology; Orbital diseases; Tomography, x-ray computed